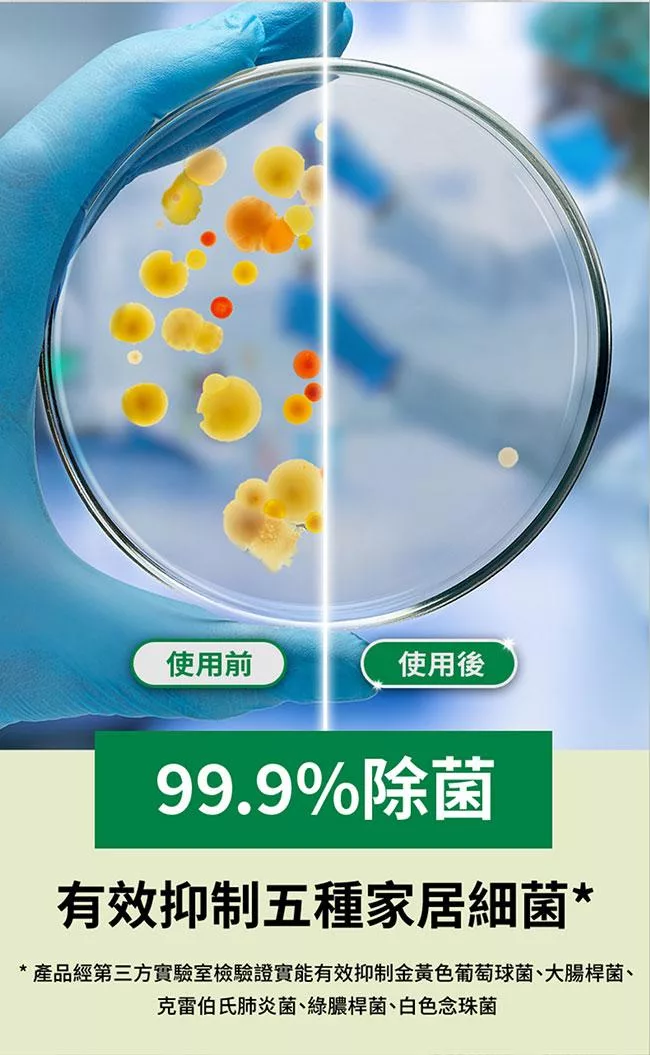

因拍攝略有色差,圖片僅供參考,顏色請以實際收到商品為準。
退換貨說明
會員所購買的商品均享有到貨十天的猶豫期(含例假日)。退回之商品必須於猶豫期內寄回。
辦理退換貨時,商品必須是全新狀態與完整包裝(請注意保持商品本體、配件、贈品、保證書、原廠包裝及所有附隨文件或資料的完整性,切勿缺漏任何配件或損毀原廠外盒)。退回商品無法回復原狀者,恐將影響退貨權益或需負擔部分費用。
訂購本商品前請務必詳閱商品退換貨原則。

醫療器材商許可執照
許可執照字號:北市衛器販(信)字第MD6201057385號
醫療器材商名稱:博客來數位科技股份有限公司
醫療器材商地址:台北市信義區忠孝東路4段560號12樓
諮詢專線:(02)-26535588
藥品/醫療器材 注意事項
消費者使用前應詳閱產品說明書。
洗衣膠囊 注意事項:
(一)避免兒童取玩,若不慎誤食,請立即飲用大量清水並送醫。
(二)若不慎誤入眼睛時,不要搓揉眼睛,請立即用水沖洗15分鐘以上,並請立即就醫。
動物應施檢疫物應注意事項
(一)為防治動物傳染病,境外動物或動物產品等應施檢疫物輸入我國,應符合動物檢疫規定,並依規定申請檢疫。擅自輸入應施檢疫物者最高可處7年以下有期徒刑,得併科新臺幣300萬元以下罰金。未依規定申請檢疫者,將課以新臺幣100萬元以下罰鍰,並得按次處罰。
(二)境外商品不得隨貨贈送應施檢疫物。
(三)收件人違反動物傳染病防治條例第34條第3項規定,未將郵遞寄送輸入之應施檢 疫物送交輸出入動物檢疫機關銷燬者,處新臺幣3萬元以上15萬元以下罰鍰。
環境用藥注意事項
(一)依環境用藥管理法不得廣告販售未經環保署登記核准之環境用藥,違者處刊登者新臺幣6萬元以上30萬元以下罰鍰。
(二)合法環境用藥應有環境用藥許可證字號,可至環保署化學局「環境用藥許可證及病媒防治業網路查詢系統」。
(三)環境用藥相關資訊可參考環保署化學局『環境用藥安全使用宣導網』。
TOP
TOP